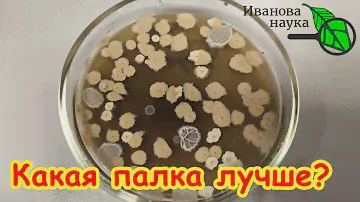

Как это работает?
1
Выбираете товар
Добавьте интересующие вас товары в корзину
2
Оформляете заказ
Заполните все поля формы, чтобы получить предложение
3
Получаете предложения
В ближайшее время с вами свяжется менеджер для уточнения деталей
горнаяАланийская горная 5 л Описание товара В чистой природной воде «Аланийская горная» вы найдете не только освежающий вкус, но и все компоненты для восполнения организма ценными минералами. Ее особенность заключается в достаточном содержании йода, крайне необходимого современным горожанам. Вода добывается на Северном Кавказе и бережно разливается в экологически чистую тару для максимального сохранения природной пользы. Пятилитровый объем – удачное решение для дома и офиса, чтобы всегда иметь запас воды для чая, кофе и питья в чистом виде.0 8080RUB80RUB
Описание товара В чистой природной воде «Аланийская горная» вы найдете не только освежающий вкус, но и все компоненты для восполнения организма ценными минералами. Ее особенность заключается в достаточном содержании йода, крайне необходимого современным горожанам. Вода добывается на Северном Кавказе и бережно разливается в экологически чистую тару для максимального сохранения природной пользы. Пятилитровый объем – удачное решение для дома и офиса, чтобы всегда иметь запас воды для чая, кофе и питья в чистом виде.0 8080RUB80RUB
 Описание товара В чистой природной воде «Аланийская горная» вы найдете не только освежающий вкус, но и все компоненты для восполнения организма ценными минералами. Ее особенность заключается в достаточном содержании йода, крайне необходимого современным горожанам. Вода добывается на Северном Кавказе и бережно разливается в экологически чистую тару для максимального сохранения природной пользы. Пятилитровый объем – удачное решение для дома и офиса, чтобы всегда иметь запас воды для чая, кофе и питья в чистом виде.0 8080RUB80RUB
Описание товара В чистой природной воде «Аланийская горная» вы найдете не только освежающий вкус, но и все компоненты для восполнения организма ценными минералами. Ее особенность заключается в достаточном содержании йода, крайне необходимого современным горожанам. Вода добывается на Северном Кавказе и бережно разливается в экологически чистую тару для максимального сохранения природной пользы. Пятилитровый объем – удачное решение для дома и офиса, чтобы всегда иметь запас воды для чая, кофе и питья в чистом виде.0 8080RUB80RUB0.00015
Аланийская горная 5 л в Мичуринске
Видео
Описание
Описание товара В чистой природной воде «Аланийская горная» вы найдете не только освежающий вкус, но и все компоненты для восполнения организма ценными минералами. Ее особенность заключается в достаточном содержании йода, крайне необходимого современным горожанам. Вода добывается на Северном Кавказе и бережно разливается в экологически чистую тару для максимального сохранения природной пользы. Пятилитровый объем – удачное решение для дома и офиса, чтобы всегда иметь запас воды для чая, кофе и питья в чистом виде.
Видео
ЧЬЯ ПАЛКА ЛУЧШЕ? Вся ПРАВДА о СЕННОЙ ПАЛОЧКЕ! Где взять самую лучшую палочку. Смотреть до конца!
ЧЬЯ ПАЛКА ЛУЧШЕ? Вся ПРАВДА о СЕННОЙ ПАЛОЧКЕ! Где взять самую лучшую палочку. Смотреть до конца!
PT6M58Strue0001-01-01 00:00:00 +0000 UTC
5 минут на заснеженном участке. Купили старую дачу
5 минут на заснеженном участке. Купили старую дачу
PT6M58Strue0001-01-01 00:00:00 +0000 UTC

Dizalya Palm Garden 5* Аланья. Пляж с секретом. Температура в октябре. Супер вечер с музыкой
Dizalya Palm Garden 5* Аланья. Пляж с секретом. Температура в октябре. Супер вечер с музыкой
PT6M58Strue0001-01-01 00:00:00 +0000 UTC

В шоке от красоты. Аланийская крепость и Кызыл Куле. Турция
В шоке от красоты. Аланийская крепость и Кызыл Куле. Турция
PT6M58Strue0001-01-01 00:00:00 +0000 UTC

Древняя Крепость Аланья Турция Средиземное море горы туризм
Древняя Крепость Аланья Турция Средиземное море горы туризм
PT6M58Strue0001-01-01 00:00:00 +0000 UTC

Отзывы
Отзывов еще нет - ваш может стать первым

